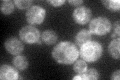
YDL092W
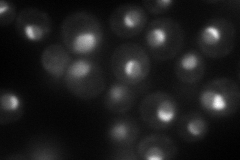
YDL092W
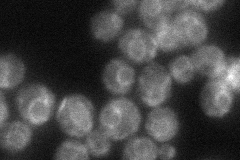
YDL092W
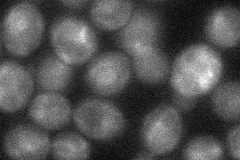
YDL092W
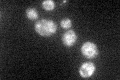
YDL092W

View description
Signal recognition particle (SRP) subunit, interacts with the RNA component of SRP to form the Alu domain, which is the region of SRP responsible for arrest of nascent chain elongation during membrane targeting; homolog of mammalian SRP14
Localization:
Intensity:
Fold change:
Significance:
-
C’ GFP library in SD
ER63.51 -
N' NOP1pr-GFP in SD
cell periphery,nucleolus88.3289 -
N' TEF2pr-mCherry in SD

nucleus,nucleolus179.813 -
N' NATIVEpr-GFP in SD
ER55.2924 -
N' TEF2pr-VC and Cyto-VN in SD
ambigous,nucleolus34.7682 -
C’ GFP library in SD+DTT

ER70.021.1No -
C’ GFP library in SD+H2O2

ER50.840.8No -
C’ GFP library in Starvation Media
ER52.430.82No -
C’ GFP library on the background of Pup2-DaMP

ER -
C’ GFP library on the background of CCT mutant

ER51.2730.807226No
